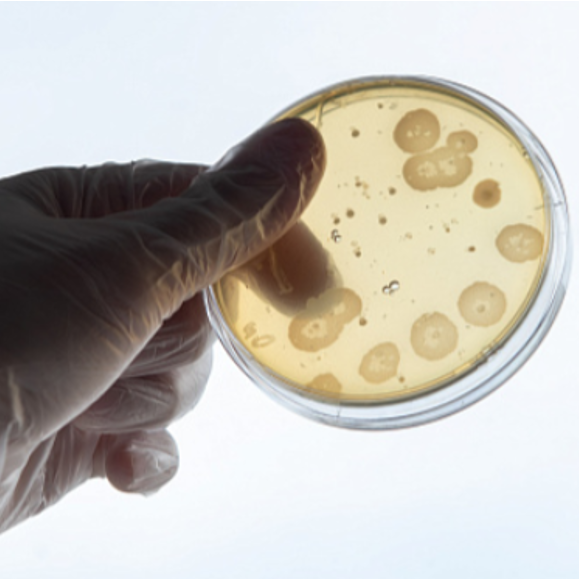
Главная

БИОИНЖЕНЕРИЯ
БИОВЕТМЕД. ДГТУ
Профиль Трансляционная биоинженерия предназначен для междисциплинарной подготовки студентов для развития стартапов в сфере биоинженерных технологий или создания биомедицинских компаний. Объектами профессиональной деятельности выпускников, освоивших программу специалитета, являются: разнообразные биологические объекты, включая измененные природные и искусственные (организмы от вирусов и одноклеточных до многоклеточных, биомакромолекулы, объекты генетической инженерии); базы данных, описывающих структуру и свойства биологических объектов (геномов, белков, нуклеиновых кислот, биоорганических соединений и их взаимодействий).
Наша группа ВКонтакте